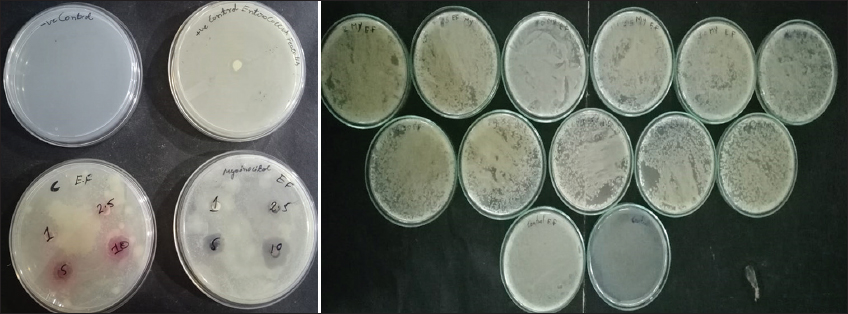
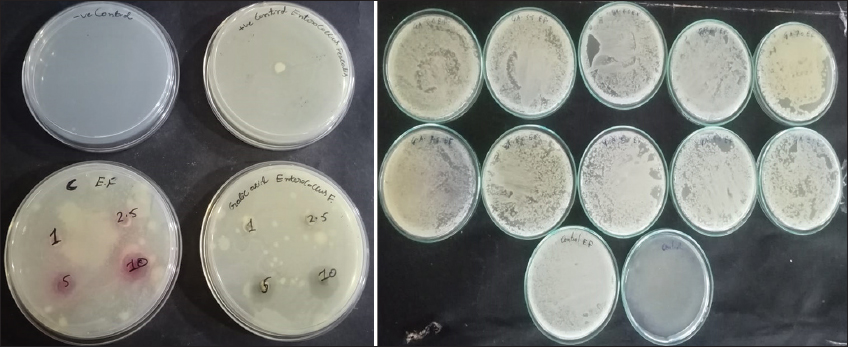
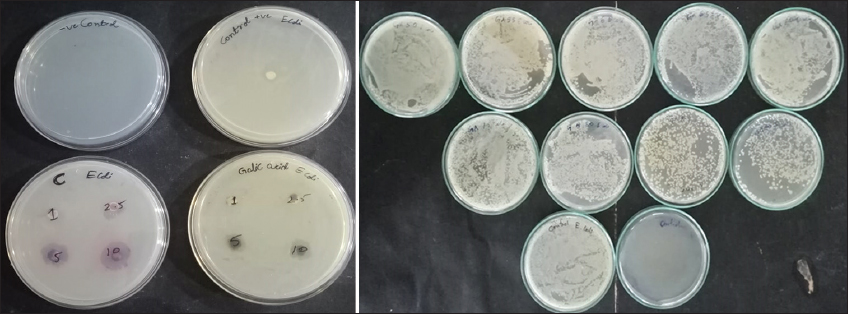
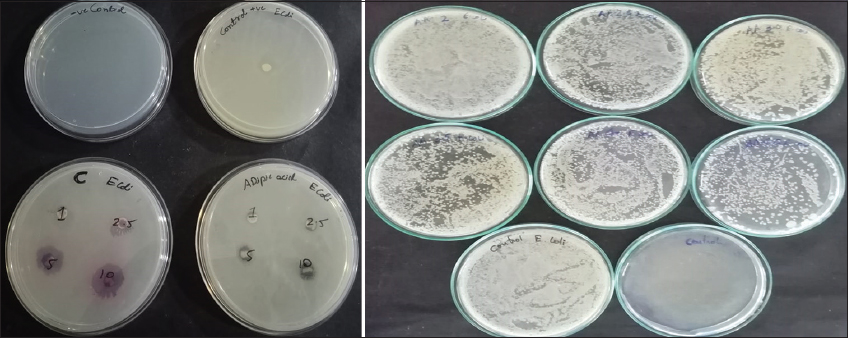
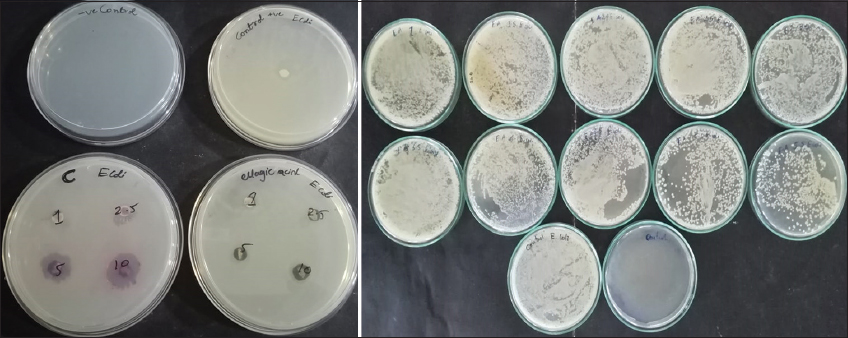
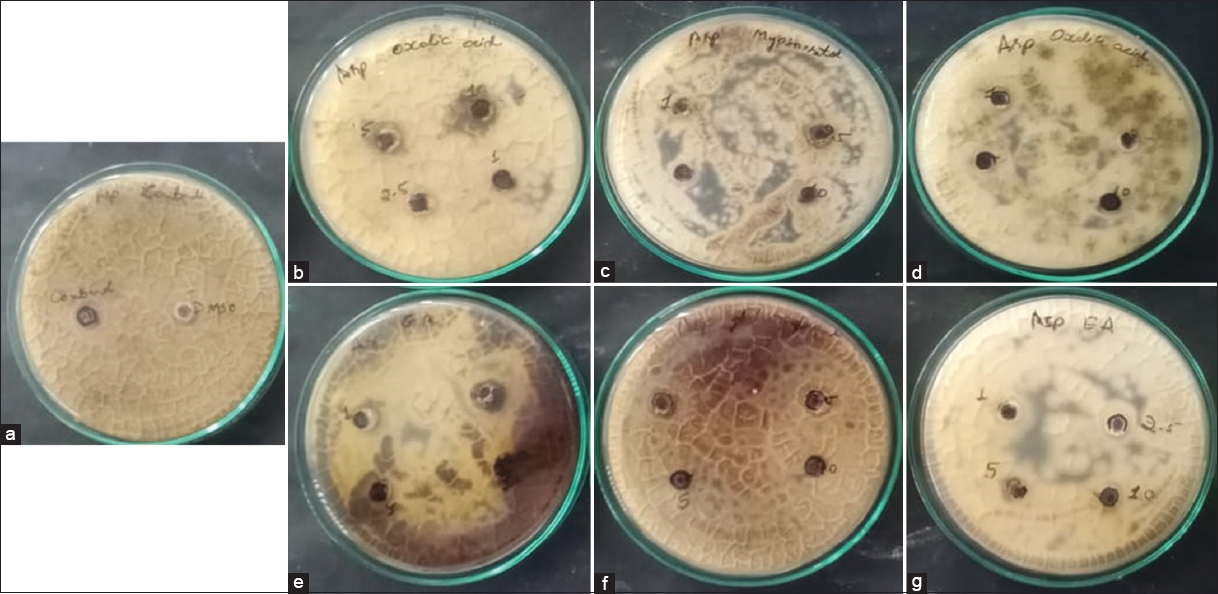
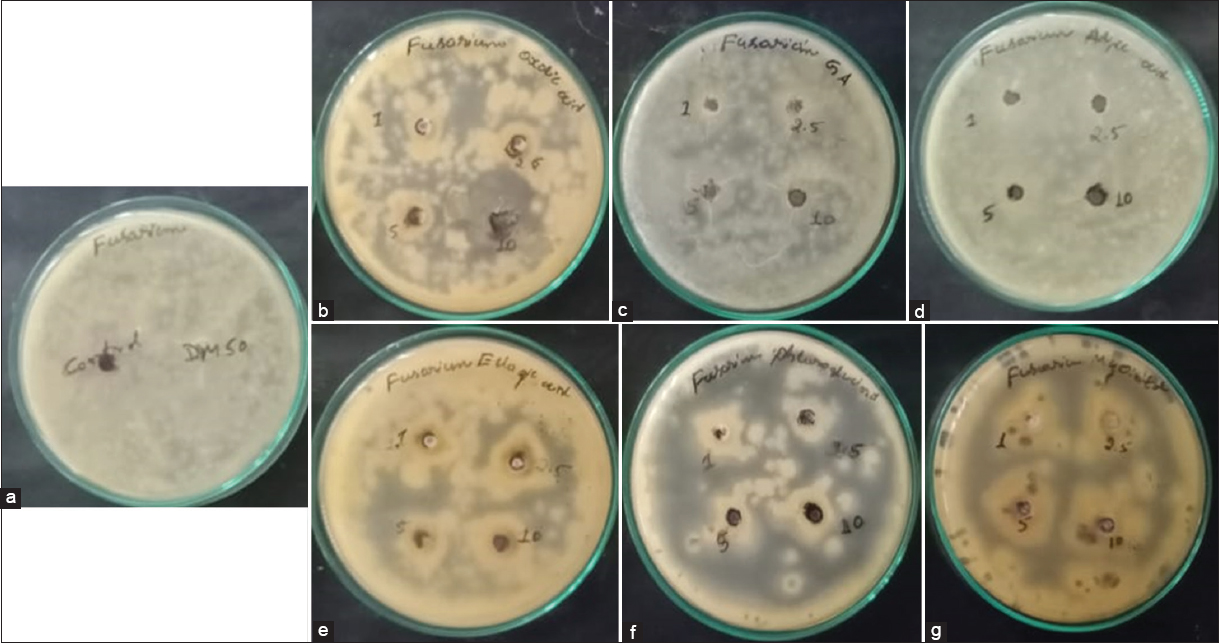
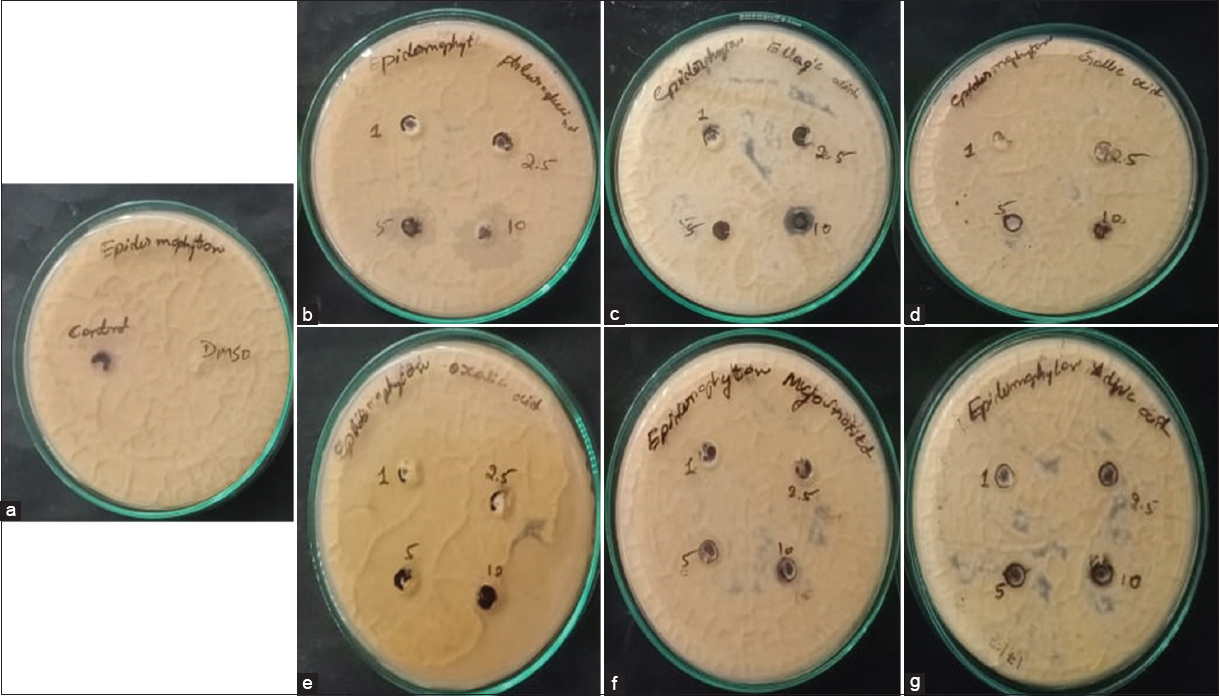

1. INTRODUCTION
Nanotechnology has evolved as a fascinating domain of research due to its potential applications in diverse areas of science and technology, such as material science, optical sensors, surface modification, catalysis, water purification, diagnostics, drug delivery systems, and nanoformulations of useful drugs [1]. Nanoparticles are often synthesized through different chemical, physical, and biochemical processes from organic and inorganic materials. Nanoparticles have a high surface-to-volume ratio, which gives them a significant advantage in a variety of applications [2-4].
Synthesis of functionalized nanomaterials and investigation of their applications for practical utility has been a leading domain of research during the past decade [5-8]. Natural products have been the source of drugs, and many of them have been successfully incorporated into nanomaterials to form functional nanocomposites [9,10]. Drug resistance of pathogenic bacteria is a global challenge in therapeutics due to the incredible adaptability of these microorganisms. This makes the research on antimicrobial drugs an evergreen domain and there is an ever-growing demand for new therapeutic agents with antimicrobial potential [11,12]. The fortification of silver nanoparticles (AgNPs) with antimicrobial phytochemical extracts has been proven as an agile process for the green synthesis of potential antimicrobial pro-drugs to combat drug-resistant microbial strains [4,13]. Quite a large number of independent studies have reported the green synthesis of AgNPs by employing several plant extracts [14-18] for different applications. It has been well documented that AgNPs exhibit antimicrobial and fungistatic efficacy [19,20]. Interestingly, few researchers have also reported the antimicrobial efficacy of AgNPs fortified with components of lower terrestrial plants like ferns [4,21]. Apart from this, many of the nanocomposites of silver in combination with natural products have been found to possess potential therapeutic applications. Anticancer, antidiabetic, anti-inflammatory, and antimicrobial activities are some of the few identified applications [4,13,22-24].
Due to its ease of synthesis, low cost, excellent electrical conductivity, optical property, and admirable stability, polyaniline (PANI) has gained significant attention in numerous emerging technologies, including energy conservation and storage, molecular electronics, and sensors [25-29]. PANI has been received by researchers as a preferred choice of material to incorporate a wide variety of functional groups and subunits, to investigate antimicrobial activities, cytotoxicity, biocompatibility, antioxidant activity, drug delivery, tissue engineering, wound healing, and biosensor applications [30]. The present study aims to synthesize silver nanoparticles functionalized natural products doped PANI (SNPs) (as depicted in Scheme 1) and to evaluate the efficiency of the natural products as dopants in combination with PANI and AgNPs against selected microbial pathogens.
 | Scheme 1. Synthesis of silver nanoparticles functionalized natural products doped PANI. [Click here to view] |
2. MATERIALS AND METHODS
2.1. Preparation of AgNPs Functionalized Natural Products Doped PANI (SNPs)
The chemicals used in the present study have been purchased from standard commercial sources. Aniline, silver nitrate, paraphenylenediamine, oxalic acid, adipic acid, and myoinositol were sourced from S.D. Fine Chemicals, ellagic acid and phloroglucinol from Sigma-Aldrich, and gallic acid from Spectrochem. SNPs were synthesized by dissolving 1 g of aniline as monomer and 0.1 equivalent of paraphenylenediamine as an initiator in 100 mL of distilled water containing 0.3 equivalent of natural products. To the above reaction mixture, three equivalents of AgNO3 dissolved in 50 mL of distilled water were added drop by drop with constant stirring. After complete addition, the reaction mixture was stirred for additional 24 h at room temperature. The product obtained was filtered, washed with water followed by methanol, and vacuum dried at 60°C for 12 h.
2.2. Characterization of SNPs
The analysis of SNPs was performed by Fourier transform infrared (FTIR), X-ray diffraction (XRD), scanning electron microscopy (SEM), and energy-dispersive X-ray spectroscopy (EDX).
2.2.1. FTIR spectroscopy
The active functional groups existing in SNPs synthesized were scrutinized by employing an FT/IR-6000 modeled FTIR spectrometer. To obtain the data, the resolution was maintained at 4 cm−1 and the wavenumber range was set between 4000 and 400 cm−1. To perform this analysis, the samples were combined with KBr to get pellets from which transmittance was observed. This analysis would provide information relating to functional groups present in as synthesized SNPs.
2.2.2. XRD
XRD was performed by ARL™ Equinox 100 modeled XRD utilizing monochromatic X-rays of Cu Ka radiation operating at 30 mA and 40 kV with 2q ranging from10° to 70°. The average crystallite size of prepared nanoparticles was analyzed by Scherrer’s formula utilizing full width at half maximum (FWHM) of the highest peak.
2.2.3. SEM and EDX
The surface morphology of prepared SNPs was determined by SEM, using Thermo Scientific Quattro ESEM with an accelerating voltage of 1 kV or 5 kV. Each sample was placed on a stub adhered with carbon tape and sputtered with gold to capture images. SEM was equipped with EDX, which was employed to examine the qualitative chemical composition of SNPs synthesized in this study.
2.3. Evaluation of the Antibacterial Activity of SNPs
2.3.1. Bacterial strains
Four different strains of bacteria were used in the study which are Escherichia coli MG 1586, Klebsiella pneumoniae MTCC 4030 (both clinically important strains), Enterococcus faecalis ATCC 29212, and Streptococcus mutans MTCC-890 (two common oral pathogens). These bacterial strains were originally procured from MTCC, Chandigarh, and maintained at the laboratory of Dextrose Technologies Pvt. Ltd., Bengaluru. E. coli and K. pneumoniae were cultured on Luria-Bertani agar/broth at 37°C. E. faecalis and S. mutans were cultured in brain heart infusion broth at 37°C. All the media used for culturing bacteria were procured from HiMedia Laboratories.
2.3.2. Well diffusion assay
The well diffusion method was used to assess the antibacterial activity of SNPs. About 150 ml pre-cultured test organisms were dispersed onto agar plates and 6 mm diameter wells in specified agar media were punched. SNPs with various concentrations (1, 2.5, 5, and 10 mg/mL) were placed on each agar plate inoculated with bacterial strains. The zone of inhibition was measured after 24 h of incubation at 37°C. Effective concentrations of the samples showing good activity were determined in terms of minimal inhibitory concentration (MIC) and minimal bactericidal concentration (MBC) by the broth dilution method.
The newly synthesized SNPs have been tested for their bacteriostatic activity by well diffusion assay on four species of bacteria, namely, E. coli, K. pneumoniae, S. mutans, and E. faecalis at concentrations of 1, 2.5, 5, and 10 mg/mL in triplicates. Amoxicillin at a concentration of 30 μg/mL was used as positive control and DMSO as a negative control. The concentrations of SNPs for the experimental trials have been chosen according to Iftikhar et al. [16]. By determining MIC and MBC, the reproducibility of the results of the zone of inhibition has been confirmed using the broth dilution method.
2.3.3. Analysis of bacterial cells treated with SNPs
The effect of SNPs on bacteria was evaluated by incubating bacterial cells in overnight cultures with different concentrations of the SNPs and imaging the treated cells. The procedure was carried out inside a biosafety cabinet until mounting of the sample. The bacterial cells were fixed using 1% paraformaldehyde and 2% glutaraldehyde (1:1) for an hour. The bacterial suspension of 100 μL was released into 5 mL of medium and filtered using a filter with a pore size of 0.08 μm. If the filter gets clogged, the suspension was diluted further and the filter was washed with diluted ethanol. Later, the filter was removed and allowed to dry at room temperature and then cut into pieces to mount on the carbon tape, which was fixed on the stub. The stub was removed from the biosafety cabinet and placed for sputtering to capture the SEM images.
2.4. Evaluation of the Antifungal Activity of SNPs
2.4.1. Fungal strains
The fungal species used in the present study include common species Aspergillus niger locally isolated from the soil and identified based on macroscopical and microscopical characters [31,32] and Fusarium oxysporum MTCC 3327 sourced from MTCC. Dermal pathogenic fungi, Epidermophyton floccosum MTCC 7880, and Trichophyton rubrum MTCC 3272 also were procured from MTCC, Chandigarh, and maintained at Dextrose Technologies laboratory.
2.4.2. Well diffusion assay
Evaluation of the antifungal activity of the SNPs was performed by well diffusion assay. About 150 μL of pre-cultured test organisms were spread onto the agar plates and wells of 6 mm in diameter were punched in specific agar media. Based on previously documented literature, various concentrations of SNPs such as 1, 2.5, 5, and 10 mg/mL were loaded into the wells [16]. Fungal plates were incubated at room temperature for 48–96 h, after which zones of inhibition were measured and tabulated.
3. RESULTS AND DISCUSSION
3.1. Characterization of SNPs
3.1.1. FTIR spectra
The FTIR spectra of AgNPs functionalized polyaniline nanocomposites (SPs) and SNPs are presented in Figure 1. The spectra of SPs indicate the presence of C-H vibration peaks at 2977 and 2896 cm−1. The C-H bending in SPs can be observed at 1398 and 1060 cm−1. SPs exhibited a C=N bond vibration peak at 1662 cm−1, C-N bond vibration at 1230 cm−1, and C=C bond vibration peaks at 1540 cm−1 [33]. Similar peaks are observed in all SNPs. In addition, ellagic acid doped SNP exhibited phenolic OH group at 3660 cm−1 and C=O stretching at 1719 cm−1 [34]. Adipic acid, gallic acid, and oxalic acid doped SNPs exhibited a broad peak at around 3400 cm−1 corresponding to carboxylic acid. Phloroglucinol and myoinositol doped SNPs showed the presence of −OH groups at 3447 cm−1 and 3362 cm−1, respectively.
 | Figure 1: FTIR spectra of SNPs (a) control – SPs, (b) adipic acid [ADP], (c) oxalic acid [OA], (d) myoinositol [MI], (e) phloroglucinol [PG], (f) gallic acid [GA], and (g) ellagic acid [EA]. [Click here to view] |
3.1.2. XRD analysis
The diffraction pattern was observed in the XRD spectrum of the SNPs, indicating their crystalline nature. The fingerprint diffraction patterns of SNPs are illustrated in Figure 2, which shows three major peaks at 2q = 37.51°, 43.12°, and 63.47° corresponding to the planes (111), (200), and (220), thereby indicating the face-centered cubic patterns of SNPs [35]. Using Scherrer’s formula, the average crystallite size of the SNPs obtained from FWHM of the more intense peak corresponding to the (111) plane located at 37.51º was determined to be ~40 nm.
 | Figure 2: XRD images of synthesized SNPs. [Click here to view] |
3.1.3. SEM and EDX analysis
The SEM images of SNPs are illustrated in Figure 3 and their respective EDX in Figure 4. The SEM images were captured with X 20,000. The surface morphology of SNPs certainly reveals the uniform and good dispersion of nanoparticles. The agglomeration of nanoparticles might have occurred because of the electrostatic interaction of SNPs. The images captured here resemble that of [36], where the morphology was spherical in appearance with aggregation as found in our analysis.
 | Figure 3: SEM images of SNPs synthesized using (a) control – SPs, (b) adipic acid, (c) ellagic acid, (d) gallic acid, (e) oxalic acid, (f) myoinositol, and (g) phloroglucinol. [Click here to view] |
 | Figure 4: EDX images of synthesized SNPs. [Click here to view] |
The qualitative and quantitative profile of elements present in the synthesized SNPs was confirmed by analysis of EDX. The spectral analysis has indicated intense signals relating to the Ag element, which further affirms the incorporation of the natural products into the AgNPs during the synthesis of the SNPs. The EDX profile of Ag at 3 keV is indicated by a strong peak, confirming it as the major elemental component of the SNPs. In addition to Ag, elements such as C and O were observed in SNPs, which can be attributed to carbon and oxygen present in the PANI and dopants.
To study the effect of SNPs on bacterial cells, overnight grown bacterial cells were treated with different concentrations of the SNPs and a change in surface morphology was observed using SEM analysis. Figure 5 illustrates the images of E. coli cells treated with SNPs doped with adipic acid and gallic acid. Loss of integrity of the cells is indicated by the uneven shapes of cells, indicating the development of cracks or ruptures on the cell wall in SNPs treated cells when compared to control. The disruption of cells was observed among SNPs treated cells of E. faecalis and S. mutans. The same is depicted in Figure 5.
 | Figure 5: SEM images of I) E. coli treated with SNPs (a) control – SPs, (b) adipic acid and (c) gallic acid; II) E. faecalis treated with SNPs (a) gallic acid and (b) myoinositol; III) S. mutans treated with SNP a) oxalic acid; and IV) E. faecalis treated with SNPs (a) gallic acid and (b) myoinositol. [Click here to view] |
3.2. Evaluation of the Antimicrobial Activity of SNPs
Bacterial infections are a significant cause of morbidity and mortality in humans [37]. In traditional medicine, crude drugs formulated from extracts of plants in combination with other natural products are used for treating bacterial infections, which impart dual benefits, inhibiting bacterial proliferation along with enhancing general immunity of the body [38]. Therefore, traditional medicines provide long-term protection against a broad spectrum of infections [39]. Contrary to this approach, modern medicine relies on isolated active compounds, synthesized or produced on a large scale, to address the issue of meeting the higher demand. This trend has led to the phenomenon of antibiotic resistance among pathogenic [40]. Recently, nanoparticles conjugated with active drug molecules have emerged as novel tools for developing antibacterial formulations [41]. A combination of natural products with green synthesized nanoparticles would be an ideal choice for drug development. This idea has prompted us to synthesize SNPs, which have both AgNPs and the natural antimicrobial qualities of organic dopants.
The microbial growth inhibition induced by SNPs has been demonstrated in selected bacterial and fungal strains. Easy methods of synthesis and enhanced efficacy demonstrated by the nanoparticles in damaging microorganisms have made them acceptable for antimicrobial applications. The reason for such an enhanced effect is the release of cations from nanoparticles while entering the cell, which causes a transformation in their normal functioning and hence kills the bacterium. Gram-negative bacteria, which possess a thin peptidoglycan layer in their cell walls when compared to Gram-positive bacteria, allow better penetration of nanoparticles and hence exhibit a larger zone of inhibition [42] in well/disk diffusion assays and the same observation was found in our present study as well.
3.2.1. Bacteriostatic activity of SNPs on E. coli and K. pneumoniae
The concentration-dependent bacteriostatic efficiency of SNPs on different strains of bacteria is depicted in Table 1. The zone of inhibition and MBC of the top three SNPs on E. coli is provided in supplementary information [Figures S1-S3]. It can be understood from the data that all SNPs except phloroglucinol showed bacteriostatic activity against E. coli. It is evident from the data that myoinositol doped SNP-treated K. pneumoniae showed growth inhibition, implying superior activity in comparison to other SNPs. Multivariate ANOVA of the MBC values of ellagic acid-doped SNP against E. coli has yielded 15.0137 as F statistic and 0.001959 as P-value for intercept and 9.7051 as F value and 0.007256 as P-value for MIC, indicating the null hypothesis to be true. In the case of oxalic acid-doped SNP, the P-value for the intercept is 0.05064, indicating that it is false and so it must be rejected whereas, the MIC did not affect the P-value (0.30005). Adipic acid-doped SNP showed a true null hypothesis [Table 2]. Multivariate ANOVA of the MIC and MBC results of the treatment of myoinositol-doped SNP on K. pneumoniae indicated 36.238 as F-statistic and 9.766 10−5 as P-value for intercept, while 11.557 as F-statistic and 0.00437 as P-value for MIC, which affirms the true null hypothesis [Table 2]. Ellagic acid-doped SNP results displayed a true null hypothesis in both intercept and MIC, which signifies that they were effective in controlling the growth of K. pneumoniae. Furthermore, to be specific, the two SNPs, that is, ellagic acid and myoinositol-doped SNP, revealed the same activity. The SNPs doped with gallic acid, adipic acid, and phloroglucinol did not show any inhibition of growth in the case of K. pneumoniae. The reason behind such interactions could be ascribed to the phytochemical properties possessed by individual SNPs that account for their ability to hinder the growth of bacteria.
Table 1: Bacteriostatic efficacy of SPs and SNPs on E. coli, K. pneumoniae, S. mutans, and E. faecalis.
| Bacterial strains | SNPs | Zone of inhibition (in mm)* | SD | |||
|---|---|---|---|---|---|---|
| 1 mg/mL | 2.5 mg/mL | 5 mg/mL | 10 mg/mL | |||
| E. coli | Gallic acid | 0 | 0 | 5.6 | 9 | 4.4 |
| Adipic acid | 0 | 5.3 | 6 | 9.3 | 3.9 | |
| Ellagic acid | 5.6 | 6.3 | 11.7 | 12.3 | 3.5 | |
| Oxalic acid | 0 | 5.6 | 7.6 | 7.6 | 3.6 | |
| Myoinositol | 0 | 0 | 7.3 | 8 | 4.4 | |
| SPs | 0 | 10 | 10 | 13 | 3.2 | |
| K. pneumoniae | Ellagic acid | 0 | 0 | 0 | 9.6 | 4.8 |
| Oxalic acid | 0 | 0 | 0 | 8 | 4 | |
| Myoinositol | 0 | 0 | 4.6 | 13.6 | 6.4 | |
| SPs | 0 | 0 | 0 | 0 | 0.0 | |
| S. mutans | Gallic acid | 0 | 9 | 9.6 | 11.3 | 5.08 |
| Ellagic acid | 0 | 0 | 8.6 | 13.6 | 6.73 | |
| Oxalic acid | 0 | 0 | 5.6 | 14 | 6.62 | |
| Phloroglucinol | 0 | 4.3 | 8 | 8.6 | 3.97 | |
| Myoinositol | 0 | 9.6 | 11.6 | 16 | 6.75 | |
| SPs | 0 | 6 | 11 | 10 | 4.6 | |
| E. faecalis | Gallic acid | 0 | 0 | 10.6 | 9.6 | 5.85 |
| Adipic acid | 0 | 0 | 8.3 | 12.3 | 6.17 | |
| Ellagic acid | 0 | 0 | 0 | 7.6 | 3.80 | |
| Oxalic acid | 0 | 0 | 0 | 12.3 | 6.150 | |
| Myoinositol | 4.3 | 5.3 | 7.6 | 11.3 | 3.11 | |
| SPs | 0 | 0 | 0 | 6 | 3.0 | |
| −ve control (DMSO) | 0 | 0 | 0 | 0 | 0.0 | |
| +ve control amoxicillin 30 mg/ml | 18 | NT | NT | NT | 0.0 | |
* Average of three replicates. NT: Not tested, E. coli: Escherichia coli, K. pneumoniae: Klebsiella pneumoniae, S. mutans: Streptococcus mutans, E. faecalis: Enterococcus faecalis
Table 2: MIC and MBC of SNPs on bacteria.
| S. No. | SNPs | E. coli | K. pneumoniae | S. mutans | E. faecalis | ||||
|---|---|---|---|---|---|---|---|---|---|
| MIC | MBC | MIC | MBC | MIC | MBC | MIC | MBC | ||
| 1. | Gallic acid | >5 | >5 | NA | NA | 1.5 | 2 | 1.5 | 2 |
| 2. | Adipic acid | 2.5 | 3 | NA | NA | NA | NA | NA | NA |
| 3. | Ellagic acid | 1 | 1.5 | >5 | >5 | >5 | >5 | >5 | >5 |
| 4. | Oxalic acid | 2.5 | 3 | NA | NA | >5 | >5 | >5 | >5 |
| 5. | Phloroglucinol | >5 | >5 | NA | NA | 5 | >5 | 5 | >5 |
| 6. | Myoinositol | >5 | >5 | >5 | >5 | 1.5 | 2 | 1.5 | 2 |
| 7. | SPs | 1.5 | 2 | NA | NA | 5 | >5 | >5 | >5 |
All values are in mg/mL. NA: No activity, E. coli: Escherichia coli, K. pneumoniae: Klebsiella pneumoniae, S. mutans: Streptococcus mutans, E. faecalis: Enterococcus faecalis, MIC: Minimal inhibitory concentration, MBC: Minimal bactericidal concentration
3.3. Evaluation of the Antimicrobial Efficacy of SNPs on Dental/Oral Pathogens
3.3.1. Bacteriostatic activity of SNPs on S. mutans
Subsequently, we have evaluated the antibacterial effect on Gram-positive dental pathogens like S. mutans. The bacteriostatic effect along with standard deviation on S. mutans due to the treatment with SNPs, SPs, and control is presented in Table 1, and it can be observed that all the SNPs have demonstrated good antibacterial activity. The MIC and MBC values of SNPs in S. mutans are illustrated in Table 2. All the samples tested on S. mutans have emerged as equally potent bacteriostatic candidates. Multivariate ANOVA of the data of myoinositol-doped SNP yielded a high F-static of 114.778 and a P-value of 1.653. This shows that the hypothesis was true and the null hypothesis was rejected. Gallic acid-doped SNP showed no effect on hypothesis testing, and phloroglucinol-doped SNP showed significant true hypothesis testing. The zone of inhibition and MBC test results for myoinositol doped SNP on S. mutans are presented in Figure 6.
| Figure 6: Zone of inhibition and MBC of myoinositol SNP by Streptococcus mutans. [Click here to view] |
3.3.2. Bacteriostatic activity of SNPs on E. faecalis
E. faecalis is another dental pathogen on which the efficacy of SNPs has been tested. The bacteriostatic efficacy of the SNPs on this pathogen is presented in Table 1. We performed the multivariate ANOVA for the results of MIC and MBC tests on this pathogen for different SNPs using Roy’s method and the results are presented in Table 2. Myoinositol-doped SNP has yielded 13.182 under F-static and 0.006372 as P value defined for intercept, while MIC showed 11.636 for F-static and 0.008612 for P-value. This indicates that the null hypothesis was tested and found to be true. The parallel evaluation was also obtained for adipic acid and gallic acid doped SNPs. The images of MIC and MBC treatment of gallic acid-doped SNP are presented in Figure 7.
| Figure 7: Zone of inhibition and MBC of gallic acid by Enterococcus faecalis. [Click here to view] |
The above results indicate that SNPs showed better antimicrobial activity than SPs and can also perform on par with the commercially available antibiotics. Nanoparticles are known to possess the tendency to react with sulfur and phosphorus predominantly present in the outer membrane of bacteria, leading to the formation of pores in the bacterial cell wall. The interaction of nanoparticles to the bacterial membrane leads to the outflow of intracellular substances which causes shrinkage and finally lysis of the cell [43]. Different mechanisms are being proposed for the mode of action of nanoparticles on bacterial cells, such as cell wall and membrane damage, intracellular penetration and damage, and oxidative stress [44]. Our attempt to control the antibiotic-resistant bacterial phenotype was found to be successful as discussed in Section 3.1.3. SNPs have been shown to break the bacterial cell wall [Figure 5], indicating that they could be used as pro-drug antibiotic candidates.
3.4. Antifungal Activity of SNPs
Fungi are found all over the world, and their pathogenic varieties are highly resistant which makes them tough to combat. Therefore, it is important to study the fungistatic activity of the SNPs, as well. A. niger is known to cause critical diseases such as aspergillosis and otomycosis, F. oxysporum can cause mycotoxicosis and skin-related infections, while E. floccosum is recognized for triggering septicity such as tinea pedis, tinea cruris, tinea corporis, and onychomycosis, and T. rubrum is noted for athlete’s foot, infections such as jock itch and ringworm. We have evaluated the effect of our SNPs against predominant pathogenic fungi A. niger, F. oxysporum, E. floccosum, and T. rubrum. The fungal virulence factor, encrypting gene rearrangements, and other similar observed behaviors are attributed to the adaptation to any stress environment [45]. It was observed from Table 3 that oxalic acid- and phloroglucinol-doped SNP exhibited better antifungal effects compared to the other SNPs. The gallic acid-, adipic acid-, and myoinositol-doped SNPs have hardly exhibited any mycostatic activity. These data are supported by Figures S4-S7 signifying the zone of inhibition exhibited by SNPs and control against individual fungal strains. Oxalic acid-doped SNP was effective against A. niger and F. oxysporum with 7.33 mm of inhibition at 5 mg/mL and 20 mm at 10 mg/mL, respectively. Ellagic acid-doped SNP inhibited the growth of E. floccosum by 12 mm at a 10 mg/mL concentration. When the fungal strains were dosed with 5 mg/mL of phloroglucinol-doped SNP, the growth inhibition of 11 mm and 9.67 mm was observed in E. floccosum and T. rubrum organisms, justifying their fungistatic activity.
Table 3: The fungistatic activity of SNPs in terms of zone of inhibition.
| S. No. | SNPs | Target fungal species | |||
|---|---|---|---|---|---|
| A. niger | F. oxysporum | E. floccosum | T. rubrum | ||
| 1. | Gallic acid | - | - | - | - |
| 2. | Adipic acid | - | - | - | - |
| 3. | Ellagic acid | - | - | 10 mg/mL (12 mm) | - |
| 4. | Oxalic acid | 5 mg/mL (7.33 mm) | 10 mg/mL (20 mm) | - | |
| 5. | Phloroglucinol | - | - | 5 mg/mL (11 mm) | 5 mg/mL (9.67 mm) |
| 6. | Myoinositol | - | - | - | - |
| 7. | SPs | - | - | - | - |
A. niger: Aspergillus niger, F. oxysporum: Fusarium oxysporum, E. floccosum: Epidermophyton floccosum, T. rubrum: Trichophyton rubrum
Organic acids can be efficiently used as antifungal agents due to their properties relating to bioactivity, polarity, and high solubility in many solvents including water [46]. There is evidence for the fact that commercial antifungals have limited utilization and also related medicinal values because of side effects and slow recovery [47], and hence, there is an urgent need to design and develop nanoparticles with better antifungal activities. Therefore, we opted to incorporate selected natural products with AgNPs and PANI to enhance their antifungal activity, which has been proved in our study through the significant difference in the antifungal activities of SNPs with those of the control samples [Table 3]. Similar observation on enhanced antifungal activity of nanomaterial reported earlier by Xia et al. [48]. Our study has demonstrated interesting results by inhibiting human and animal pathogenic fungi, indicating their potential as alternatives to commercial antifungal products.
4. CONCLUSION
Our investigation is directed toward the synthesis of the natural products as dopants in combination with redox-active PANI and AgNPs and to evaluate antimicrobial and antifungal activities against selected microbial pathogens. Based on the outcomes of the bioassays, myoinositol- and gallic acid-doped SNPs have been found effective against dental pathogens compared to SPs. Ellagic acid-doped SNP was effective against E. coli. In addition, the antifungal activities of the SNPs have also been assessed by in vitro bioassays against four fungal species, including dermal pathogens. It was evident from our study that, when compared to SPs, the SNPs exhibited better antifungal activity. Oxalic acid-doped SNP showed good inhibition against the growth of common fungi A. niger and F. oxysporum. The effective arrest of dermal pathogens E. floccosum and T. rubrum was observed on SNP-doped phloroglucinol. Our investigation into the antimicrobial properties of AgNPs in combination with natural products and redox-active polyaniline hybrid materials has yielded encouraging results when compared with AgNPs-polyaniline nanocomposite without dopants, indicating their scope in therapeutic domains. These findings can provide a profound impact on combating the antibiotic-resistant strains of pathogenic bacteria. More focused and in-depth investigations in these areas are warranted to reap the full benefits of this finding.
5. AUTHORS’ CONTRIBUTIONS
All authors made substantial contributions to conception and design, acquisition of data, or analysis and interpretation of data; took part in drafting the article or revising it critically for important intellectual content; agreed to submit to the current journal; gave final approval of the version to be published; and agreed to be accountable for all aspects of the work. All the authors are eligible to be an author as per the International Committee of Medical Journal Editors (ICMJE) requirements/guidelines.
6. FUNDING
Harish M. N. K. acknowledges the financial support from DST-SERB (CRG/2018/003792).
7. CONFLICTS OF INTEREST
There are no financial or other conflicts of interest reported by the authors in this study.
8. ETHICAL APPROVALS
This research does not include any animal or human subjects.
9. DATA AVAILABILITY
All data generated and analyzed are included within this research article and its supplement data.
10. PUBLISHER’S NOTE
This journal remains neutral with regard to jurisdictional claims in published institutional affiliation.
REFERENCES
1. Yetisgin AA, Cetinel S, Zuvin M, Kosar A, Kutlu O. Therapeutic nanoparticles and their targeted delivery applications. Molecules 2020;25:2193. [CrossRef]
2. Baig N, Kammakakam I, Falath W. Nanomaterials:A review of synthesis methods, properties, recent progress, and challenges. Mater Adv 2021;2:1821-71. [CrossRef]
3. Zhang D, Ma XL, Gu Y, Huang H, Zhang GW. Green synthesis of metallic nanoparticles and their potential applications to treat cancer. Front Chem 2020;8:1-18. [CrossRef]
4. Dada AO, Adekola FA, Dada FE, Adelani-Akande AT, Bello MO, Okonkwo CR,
5. Delfi M, Ghomi M, Zarrabi A, Mohammadinejad R, Taraghdari ZB, Ashrafizadeh M,
6. Ren Q, Ga L, Lu Z, Ai J, Wang T. Aptamer-functionalized nanomaterials for biological applications. Mater Chem Front 2020;4:1569-85. [CrossRef]
7. Mitchell MJ, Billingsley MM, Haley RM, Wechsler ME, Peppas NA, Langer R. Engineering precision nanoparticles for drug delivery. Nat Rev Drug Discov 2021;20:101-24. [CrossRef]
8. Mathew T, Sree RA, Aishwarya S, Kounaina K, Patil AG, Satapathy P,
9. Patra JK, Das G, Fraceto LF, Campos EV, Rodriguez-Torres MD, Acosta-Torres LS,
10. Atta UR, Iqbal MC. Frontiers in Anti-infective Drug Discovery. Vol. 8. Singapore:Bentham Science Publishers;2020.
11. Leon-Buitimea A, Garza-Cárdenas CR, Garza-Cervantes JA, Lerma-Escalera JA, Morones-Ramirez JR. The demand for new antibiotics:Antimicrobial peptides, nanoparticles, and combinatorial therapies as future strategies in antibacterial agent design. Front Microbiol 2020;11:1669. [CrossRef]
12. Prasad A, Devi AT, Prasad MN, Zameer F, Shruthi G, Shivamallu C. Phyto anti-biofilm elicitors as potential inhibitors of
13. Younis NS, El Semary NA, Mohamed ME. Silver nanoparticles green synthesis via
14. Gupta D, Chauhan P. Green synthesis of silver nanoparticles involving extract of plants of different taxonomic groups. J Nanomed Res 2017;5:00110. [CrossRef]
15. Vanlalveni C, Lallianrawna S, Biswas A, Selvaraj M, Changmai B, Rokhum SL. Green synthesis of silver nanoparticles using plant extracts and their antimicrobial activities:A review of recent literature. RSC Adv 2021;11:2804-37. [CrossRef]
16. Iftikhar M, Zahoor M, Naz S, Nazir N, Batiha GE, Ullah R,
17. Loo YY, Rukayadi Y, Nor-Khaizura MA, Kuan CH, Chieng BW, Nishibuchi M,
18. Yin IX, Zhang J, Zhao IS, Mei ML, Li Q, Chu CH. The antibacterial mechanism of silver nanoparticles and its application in dentistry. Int J Nanomed 2020;15:2555-62. [CrossRef]
19. Bruna T, Maldonado-Bravo F, Jara P, Caro N. Silver nanoparticles and their antibacterial applications. Int J Mol Sci 2021;22:7202. [CrossRef]
20. Mussin JE, Roldan MV, Rojas F, Sosa MD, Pellegri N, Giusiano G. Antifungal activity of silver nanoparticles in combination with ketoconazole against
21. Patil AG, Kounaina K, Aishwarya S, Harshitha N, Satapathy P, Hudeda SP,
22. Andleeb S, Tariq F, Muneer A, Nazir T, Shahid B, Latif Z,
23. Karthika V, AlSalhi MS, Devanesan S, Gopinath K, Arumugam A, Govindarajan M. Chitosan overlaid Fe3O4/rGO nanocomposite for targeted drug delivery, imaging, and biomedical applications. Sci Rep 2020;10:1-7. [CrossRef]
24. Femi-Adepoju AG, Adepoju AO, Fatoba PO, Olayemi VT. Biosynthesis, characterization and antimicrobial potency of silver nanoparticles fabricated from
25. Li Z, Gong L. Research progress on applications of polyaniline (PANI) for electrochemical energy storage and conversion. Materials 2020;13:548. [CrossRef]
26. Gaikwad P, Devendrachari MC, Thimmappa R, Paswan B, Raja Kottaichamy A, Kotresh HM,
27. Sudhakara SM, Devendrachari MC, Kotresh HM, Khan F. Silver nanoparticles decorated phthalocyanine doped polyaniline for the simultaneous electrochemical detection of hydroquinone and catechol. J Electroanal Chem 2021;884:115071. [CrossRef]
28. Sudhakara SM, Devendrachari MC, Kotresh HM, Khan F. Phthalocyanine pendented polyaniline via amide linkage for an electrochemical sensing of H2O2. Microchem J 2021;161:105781. [CrossRef]
29. Sudhakara SM, Kotresh HM, Devendrachari MC, Khan F. Synthesis and electrochemical investigation of tetra amino cobalt (II) phthalocyanine functionalized polyaniline nanofiber for the selective detection of dopamine. Electroanalysis 2020;32:1807-17. [CrossRef]
30. Zare EN, Makvandi P, Ashtari B, Rossi F, Motahari A, Perale G. Progress in conductive polyaniline-based nanocomposites for biomedical applications:A review. J Med Chem 2019;63:1-22. [CrossRef]
31. Aneja KR. Experiments in Microbiology Plant Pathology and Biotechnology. 4th ed. New Delhi:New Age International Publishers;2003.
32. McClenny N. Laboratory detection and identification of
33. Butoi B, Groza A, Dinca P, Balan A, Barna V. Morphological and structural analysis of polyaniline and poly (o-anisidine) layers generated in a DC glow discharge plasma by using an oblique angle electrode deposition configuration. Polymers 2017;9:732. [CrossRef]
34. Mady FM, Shaker MA. Enhanced anticancer activity and oral bioavailability of ellagic acid through encapsulation in biodegradable polymeric nanoparticles. Int J Nanomed 2017;12:7405-17. [CrossRef]
35. Azizian-Shermeh O, Einali A, Ghasemi A. Rapid biologically one-step synthesis of stable bioactive silver nanoparticles using Osage orange (
36. Jogaiah S, Kurjogi M, Abdelrahman M, Hanumanthappa N, Tran LS.
37. Ngemenya MN, Djeukem GG, Nyongbela KD, Bate PN, Babiaka SB, Monya E,
38. Rahaman A, Choudhary MI, Yousuf S. Science of Spices and Culinary Herbs-latest Laboratory, Pre-clinical, and Clinical Studies. Vol. 2. Singapore:Bentham Science Publishers;2020.
39. Barbieri R, Coppo E, Marchese A, Daglia M, Sobarzo-Sánchez E, Nabavi SF,
40. Gorniak I, Bartoszewski R, Kroliczewski J. Comprehensive review of antimicrobial activities of plant flavonoids. Phytochem Rev 2019;18:241-72. [CrossRef]
41. Satapathy P, Khan K, Devi AT, Patil AG, Govindaraju AM, Gopal S,
42. Naraginti S, Li Y. Preliminary investigation of catalytic, antioxidant, anticancer and bactericidal activity of green synthesized silver and gold nanoparticles using
43. Shaban M, Rabia M, Fathallah W, El-Mawgoud NA, Mahmoud A, Hussien H,
44. Roy A, Bulut O, Some S, Mandal AK, Yilmaz MD. Green synthesis of silver nanoparticles:Biomolecule-nanoparticle organizations targeting antimicrobial activity. RSC Adv 2019;9:2673-702. [CrossRef]
45. Kumari M, Giri VP, Pandey S, Kumar M, Katiyar R, Nautiyal CS,
46. Guimaraes A, Venancio A, Abrunhosa L. Antifungal effect of organic acids from lactic acid bacteria on
47. Kuppusamy P, Yusoff MM, Maniam GP, Govindan N. Biosynthesis of metallic nanoparticles using plant derivatives and their new avenues in pharmacological applications-an updated report. Saudi Pharm J 2016;24:473-84. [CrossRef]
48. Xia ZK, Ma QH, Li SY, Zhang DQ, Cong L, Tian YL,
SUPPLEMENTARY INFORMATION
Silver nanoparticles decorated natural products doped polyaniline hybrid materials for biomedical applications
| Figure S1: Zone of inhibition and MBC of gallic acid SNP by Escherichia coli. [Click here to view] |
| Figure S2: Zone of inhibition and MBC of adipic acid SNP by Escherichia coli. [Click here to view] |
| Figure S3: Zone of inhibition and MBC of ellagic acid SNP by Escherichia coli. [Click here to view] |
| Figure S4: Zone of inhibition of SNPs on Aspergillus niger (a) control – SPs, (b) oxalic acid, (c) myoinositol, (d) adipic acid, (e) gallic acid, (f) phloroglucinol, and (g) ellagic acid. [Click here to view] |
| Figure S5: Zone of inhibition of SNPs on Fusarium oxysporum (a) control – SPs, (b) oxalic acid, (c) gallic acid, (d) adipic acid, (e) ellagic acid, (f) phloroglucinol, and (g) myoinositol. [Click here to view] |
| Figure S6: Zone of inhibition of SNPs on Epidermophyton floccosum (a) control – SPs, (b) phloroglucinol, (c) ellagic acid, (d) gallic acid, (e) oxalic acid, (f) myoinositol, and (g) adipic acid. [Click here to view] |
 | Figure S7: Zone of inhibition of SNPs on Trichophyton rubrum (a) control – SPs, (b) phloroglucinol, (c) ellagic acid, (d) gallic acid, (e) myoinositol, (f) sadipic acid, and (g) oxalic acid. [Click here to view] |